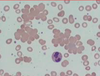

(17) Immunoassays Flashcards
1
Q
- What are assay procedures that use antibodies or antigens as specific reagents?
- What are the two major applications (one of which has three subpoints)?
A
- immunoassays
- infectious disease diagnosis and immunocompetence determinations (antibody detection (seroconversion), antigen detection, and evaluating cellular immune function)
2
Q
1-4. There are many sources of variation in immune based assays: what are they?
A
- physical state of patient (obesity, diet, activity, fitness, age)
- specimen collection (site, time of collection, contamination)
- specimen processing (transport, storage)
- YOU (follow directions, use correct conditions)
3
Q
- What is the measure of the concentration of an antibody in a serum sample? Measured by what? It is expressed as what?
- What is a titer in the picture? Why?

A
- titer; serial dilution of the sample; as a dilution to reach an endpoint of “no reaction.”
- 1:160; last titer to give a positive response
4
Q
(Blood smear)
- Which one of these neutrophils is mature (in the picture)? how do you know?
- What can antibodies cause RBC to do in blood smears? What disease could cause this?

A
- the two with the more segmented nuclei; their nuclei are segmented (younger one in the middle has a band nuclei)
- clump together; autoimmune hemolytic anemia
5
Q
- What is blood minus cells?
- What is the fluid component of clotted blood? What else does it contain?

A
- plasma
- serum; antibodies and complement proteins; but no cells or clotting factors

6
Q
- What is the percent of blood that is red blood cells? Is it a ratio?
- How is it done?
- When heparinized blood (heparin is an anticoagulant) is centrifuge, the RBC get packed at the bottom, while the plasma is left at the top. What is the hematocrit?
A
- hematocrit; yes
- centrifuging (Solid and liquid separate)
- The ratio of the volume of packed RBC to total blood volume

7
Q
(Monoclonal antibodies)
- an antibody preparation that is specific for what?
- Produced by what?
- Are all antibodies in preparation identical?
- B cells fuse with what to do this? What do you have to do after this?
A
- for a single epitope
- B cell hybridomas
- yes
- tumor cells; pick out the one that is secreting the antibody you want (then replicate away)
8
Q
(Immune Based Tests)
- Can detect either presence of what or what?
(Here are some examples)
- Precipitation assays (precipitation, agglutination, immunodiffusion)
- Enzyme Linked Immunosorbent assay (ELISA) (simple and competitive)
- Immunofluorescence, immunohistochemistry
- complement fixation
- western blotting
- Can detect the presence/activity of what?
- fluorescence activated cell sorting
- funcitonal tests (CTL, proliferation, DTH)
A
- antigen or antibody
- immune cells
9
Q
(Precipitation Assays)
- Precipitation Assays use the ability of ….?
- When does the best immunoprecipitation occur? What is this zone called?
- What zone is it when too much antibody is present? What happens here?
- What zone when too little anti-body? What occurs?
- How do you reach equivalence?
- What do you vary?
A
- antibody-antigen complexes to become insoluble
- when the concentration of the antibody and antigen is 1:1 ; the equivalence zone
- prozone; cross-linking does not occur
- post-zone; no cross-linking
- do dilutions of sample to account for zone of equivalence (cloudiness measured by light scatter)
- antigen (maybe other way somtimes though)

10
Q
- What is it called when antibody-antigen precipitation occurs on a slide?
- What are you sacrificing for speed and cost of these tests?
- How is blood typing usually done?
- RBC’s of different blood groups have unique whats on their surface? What can these be targeted by?
- How many blood types?
Cat, Dog, cows, pigs, horses
A
- agglutination
- accuracy
- agglutination
- sugar modifications; antibodies for an agglutination RXN
- 3, 8, 1, 1, 7
11
Q
- What is the test called for when you are looking for autoimmune-hemolytic anemia (animal has antibodies against their own RBC)
(Procedure)
- Same amount of blood is placed in each well. Then decreasing amounts of what are added?
A
- Coombs test
- The Coomb’s reagent (anti-antibody or anti-C3 antibodies) is added
look at slide too

12
Q
- What is another name for Immunodiffusion (precipitin) test?
- If the ring appears is does the patient have th eantibody>
A
- the ring test
- yes
look at slie

13
Q
Agarose gel immunodiffusion
just read this one (and the next slide too) (and the next one) (and the next one)
why the multiple bands in slide two? cause there could be two seperate epitopes being acted against
Where do precipitin lines form? where there is a 1:1 ratio of antibody to antigen

A
14
Q
- What is it called when they measure the radius of the circle that is produced by placed rings containing antigen into agarose gel?
- Where does the precipitin line form in aragose gel immunodiffusion?
A
- radial immunodiffusion
- where there is a 1:1 ratio of antigen to antibody
15
Q
- What does ELISA stand for?
- To detect presence of antigens, what is fixed to a plastic well?
- What else is added?
- What occurs if the antigen is present?
- What is used to detect retention (positive test)? What is this type referred to as?
- Does ElISA give you more sensitivity?
- Also learn sandwich ELISA (look at picture)

A
- Enzyme-Linked Immunosorbent Assay
- a protein
- a serum sample to be tested
- the Ab binds and unbound Abs are washed away
- an enzyme linked to a second antibody to give color; indirect ELISA
6, yes
Read this slide too

16
Q
read this slide too

A
and the next one

17
Q
just read the slides
A
18
Q
A